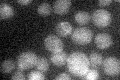
YJL045W
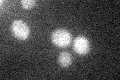
YJL045W

View description
Minor succinate dehydrogenase isozyme; homologous to Sdh1p, the major isozyme reponsible for the oxidation of succinate and transfer of electrons to ubiquinone; induced during the diauxic shift in a Cat8p-dependent manner
Localization:
Intensity:
Fold change:
Significance:
-
C’ GFP library in SD
below threshold15.3 -
N' NOP1pr-GFP in SD

mitochondria120.055 -
N' TEF2pr-mCherry in SD

punctate,mitochondria19.5379 -
N' NATIVEpr-GFP in SD

below threshold20.5166 -
N' TEF2pr-VC and Cyto-VN in SD

#N/A0 -
C’ GFP library in SD+DTT

cytosol15.351No -
C’ GFP library in SD+H2O2
cytosol14.140.92No -
C’ GFP library in Starvation Media

cytosol18.971.23No -
C’ GFP library on the background of Pup2-DaMP

below threshold -
C’ GFP library on the background of CCT mutant

below threshold14.51370.948267No
